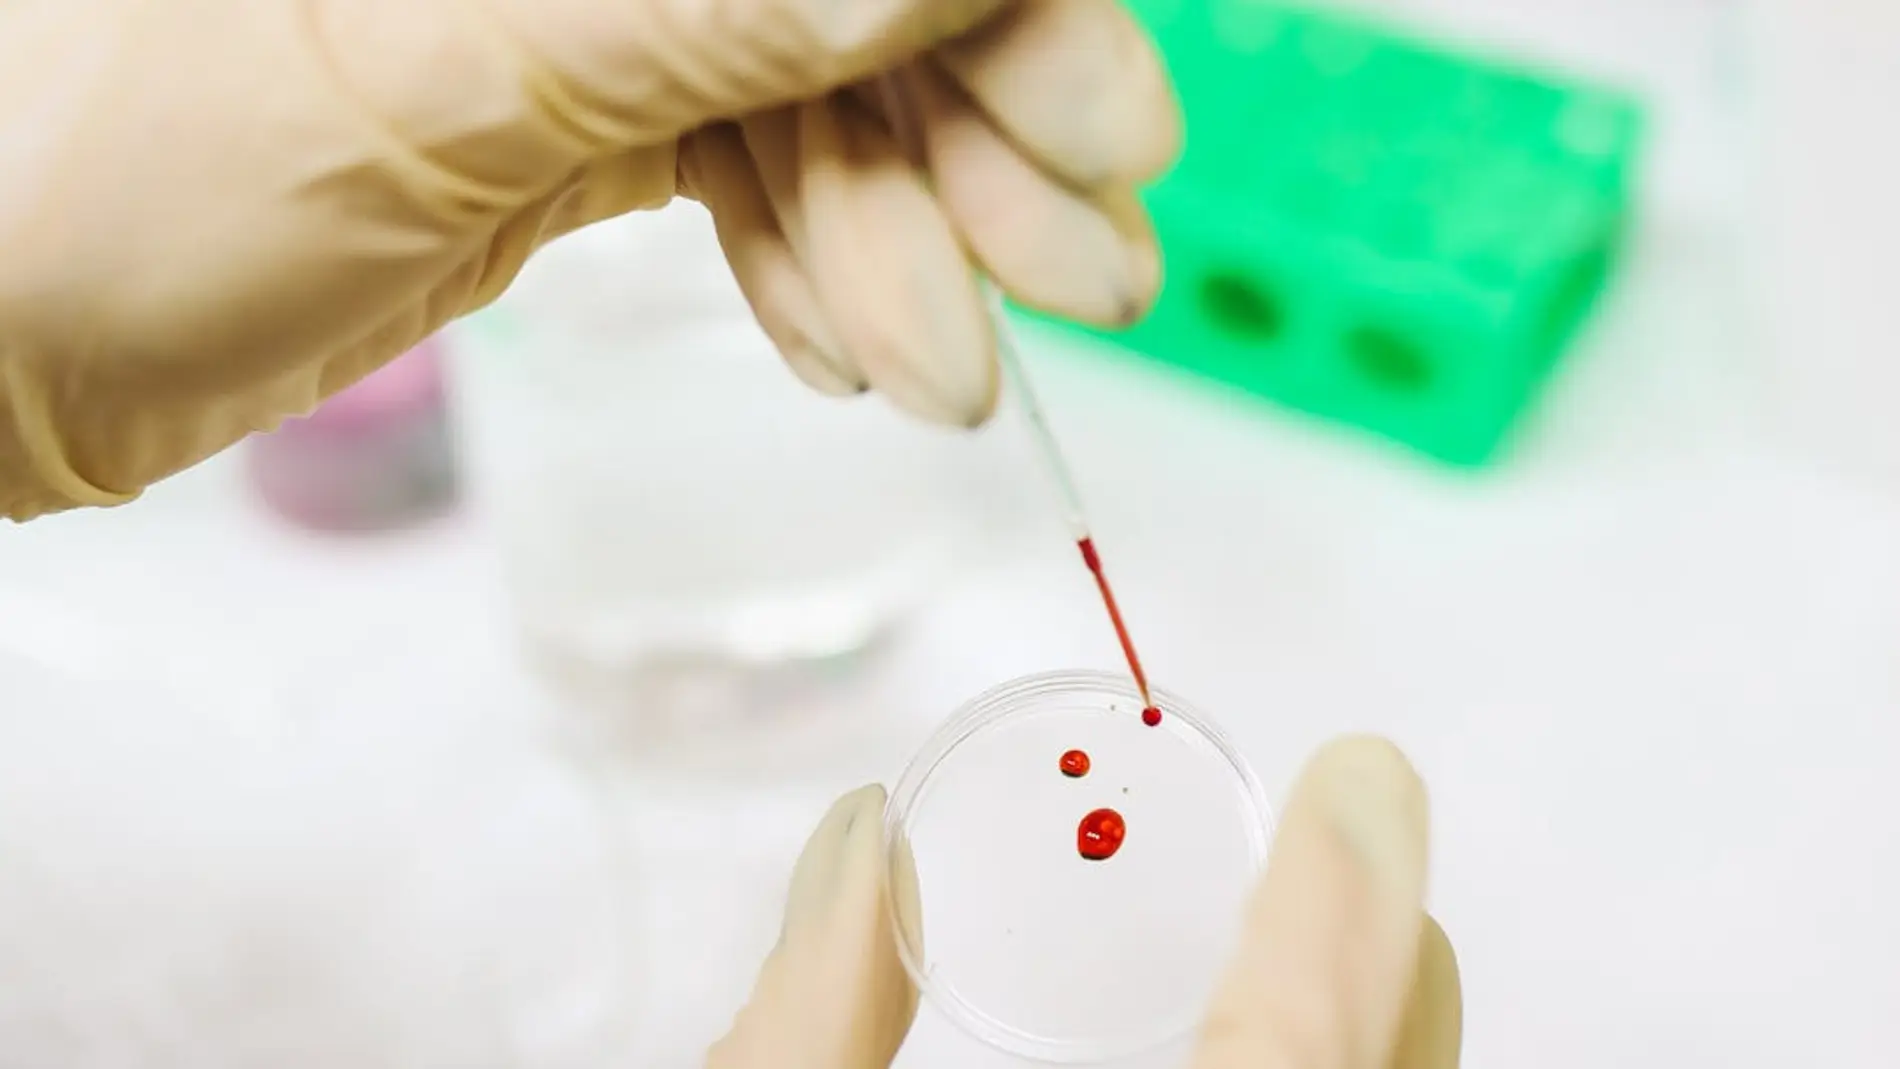

Asesinato
Una muestra de ADN en una pajita revela al presunto asesino de un misterioso crimen cometido hace 41 años
Los investigadores, en febrero de 2024, recuperaron una taza y una pajita que el sospechoso había tirado tras beber un batido en un café del condado de Suffolk. Las muestras coincidieron con el perfil genético del cuerpo de Fusco en 1984.
Publicidad
Una muestra de ADN hallada en una pajita ha conducido esta semana a la imputación de Richard Bilodeau, de 63 años, por el asesinato de Theresa Fusco, una joven de 16 años que desapareció y fue hallada muerta en 1984 en el condado neoyorquino de Nassau.
El caso de la joven fue impactante para la localidad de Lynbrook, en la que trabajaba a tiempo parcial en una pista de patinaje. Su cuerpo apareció semanas después, cubierto de hojas en una zona con árboles.
Según la fiscalía del condado de Nassau, los investigadores siguieron a Bilodeau durante meses tras recibir "múltiples pistas" que lo vinculaban con el crimen. En febrero de 2024, recuperaron una taza y una pajita que el sospechoso había tirado tras beber un batido en un café del condado vecino de Suffolk. Las muestras coincidieron con el perfil genético del cuerpo de Fusco en 1984.
La investigación inicial derivó en la condena de tres hombres, que pasaron varios años en prisión hasta que fueron liberados en 2003 debido al avance de las pruebas genéticas. Los acusados denunciaron al Estado de Nueva York, y dos de ellos recibieron indemnizaciones de 18 millones de dólares cada uno por el encarcelamiento injusto.
Detención de Bilodeau
Richard Bilodeau, que en ese momento tenía 23 años y vivía con sus abuelos, fue detenido y acusado de dos cargos de asesinato. En su comparecencia ante el tribunal, se declaró no culpable y fue enviado a prisión preventiva. Su abogado, Jason Russo, no quiso hacer declaraciones tras el primer contacto con su cliente.
La fiscal del condado, Anne Donnelly, destacó que el caso demuestra la persistencia de la justicia: "El pasado no se olvida. Esta imputación prueba que, por mucho que pase el tiempo, nunca dejaremos de luchar por las víctimas". La desaparición de Theresa Fusco coincidió con la de otras dos adolescentes del mismo entorno. Además, una de ellas era amiga suya, lo que aumentó el impacto mediático en 1984.
El fiscal adjunto Jared Rosenblatt recordó una frase que el acusado habría dicho cuando fue detenido: "Sí, en aquella época hubo gente que se libró de cargos de asesinato". A lo que Rosenblatt añadió: "Pues bien, señor Bilodeau, es 2025, y ha llegado su día de rendición de cuentas", afirmó el fiscal.
Más Noticias
Publicidad








